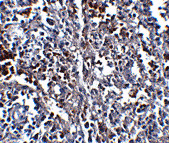
产品细节图片2

相关产品推荐更多 >
万千商家帮你免费找货
0 人在求购买到急需产品
- 详细信息
- 文献和实验
- 技术资料
- 免疫原:
Raised against a 16 amino acid peptide from near the carboxy terminus of human ORAI1.
- 形态:
liquid
- 保存条件:
Store at -20˚C
- 克隆性:
Monoclonal
- 适应物种:
Human;Mouse;Rat
- 保质期:
12 months
- 抗原来源:
Mouse
- 供应商:
南京赛戈巍生物科技有限公司
- 宿主:
Mouse
- 应用范围:
ELISA WB IHC
- 靶点:
Uniprot:Q96D31
- 抗体英文名:
ORAI1 Monoclonal Antibody
- 规格:
50ul/100ul
配方:Supplied in PBS containing 0.02% sodium azide.
图片:

Western blot analysis of ORAI1 in human ovary tissue lysate with ORAI1 antibody at (A) 1 and (B) 2 ug/mL.
,
Immunohistochemistry of ORAI1 in human spleen tissue with ORAI1 antibody at 2.5 ug/mL.
,

Immunofluorescence of ORAI1 in rat spleen tissue with ORAI1 antibody at 5 μg/ml.
风险提示:丁香通仅作为第三方平台,为商家信息发布提供平台空间。用户咨询产品时请注意保护个人信息及财产安全,合理判断,谨慎选购商品,商家和用户对交易行为负责。对于医疗器械类产品,请先查证核实企业经营资质和医疗器械产品注册证情况。
 文献和实验
文献和实验指仅对一种抗原决定基的纯粹的抗体。这类抗体不可能通过将抗原 胞的 Hybridoma,在试管内制成了纯粹的单克隆抗体。用某种抗原使动物产生免疫感应,对应于抗原之不同部分可制成各种不同的抗体复合体。然而,因为一个产生抗体的细胞,只能产生一种抗体,所以骨髓肿瘤细胞与产生抗体细胞间的细胞杂种,可形成边产生抗体边增殖的 hybridoma,将每个杂种细胞进行克隆(无性繁殖系)培养,则一个克隆的细胞群只由单种类产生同一抗体的细胞所组成,这样得到的就是单克隆抗体。此抗体在测定
Monoclonal Antibody Production
Order 6 six week old Balb/C mice and let the ARC know they are coming.Have your antigen ready for when they arrive.Once they get there earmark the mice and perform a pre-bleed on them to be used as an ELISA control for monitoring the titer
Monoclonal Antibody-Based Immunoassays
An immunoassay may be defined as an assay that employs an immunological reagent, usually an antibody, to confer specificity for the ligand being measured. As a corollary to this, the discovery, and subsequent development, of monoclonal
 技术资料
技术资料暂无技术资料 索取技术资料





![MFN1 Antibody[35813]](https://img1.dxycdn.com/p/s14/2025/0922/359/6146153295428599691.jpg!wh200)
![DPYSL4 Conjugated Antibody[C36805]](https://img1.dxycdn.com/p/s14/2025/0923/278/4431488150116040791.jpg!wh200)
![TCN2 Antibody[43039]](https://img1.dxycdn.com/p/s14/2025/0922/568/0046652811090600791.jpg!wh200)

